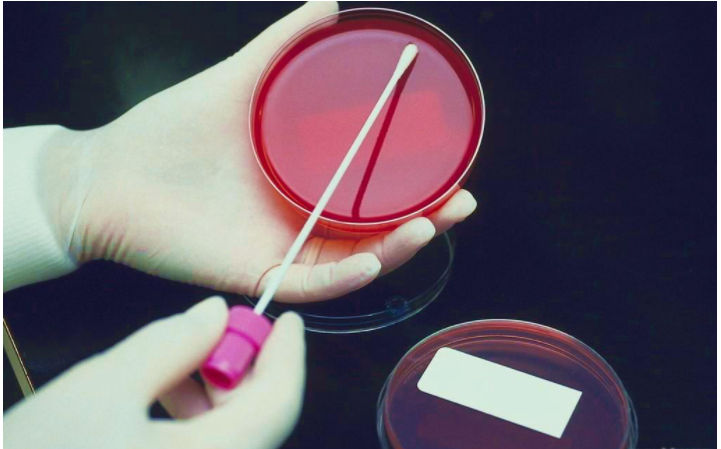

香港作为一个国际的金融中心,除了有些繁华的金融贸易,同时还有着一个让大家非常认可的东西,那便是其医疗水平。了解其基因遗传方面是否隐藏着问题,从而达到防范于未然的效果。那么应该有很多朋友都想要知道哪里的这个比较好,香港亲子鉴定费用多少。
一、选择实力比较好的医院
选择香港亲子鉴定机构医院,当然要先从实力看。香港地区在检测性别这项技术上的发展还是比较快,很好地满足了广大单身人士们的需求,帮助轻松搞定。在实际进行的时候也都应该要先有一定了解,看好不同医院的运作发展以及技术情况,是否有好的口碑评价,是否有好的综合运作等,都要做好相应了解,减少出现问题的可能。可以通过网络上的介绍或者是有过检测经验人士的介绍说明,相对来说也都可以比较好地保障自我安全性,避免很多问题出现。
二、根据自己的时间,选择可以提前预约的
去香港进行亲子鉴定,朋友们可能想知道香港亲子鉴定费用多少?也是需要注意提前预约,现在去香港鉴定的人很多,为保障自我鉴定的顺利进行,还是有必要提前联系。在母体孕期6周以后就可以验血检测,因此在这之前就要与机构联系好,以免耽误自己的实际检测进行。亲子鉴定医院的选择可以通过各大平台了解,这对有鉴定需要的人士们来说也都可以先做好相应了解,尽量能够保障自我实际检测效益,了解胎儿的性别,也可以早点知道胎儿的健康情况,以免影响实际生产。
香港的医疗水平也是我们中国非常拔尖的省份之一。因此,许多准妈妈在经济条件充足的情况下也会选择去香港进行生产。同时一项亲子鉴定服务,在香港也非常的盛行。这项香港亲子鉴定机构服务,除了能够鉴定孩子是否是自己亲生的,还可以对出生的孩子进行一个充分的检查。